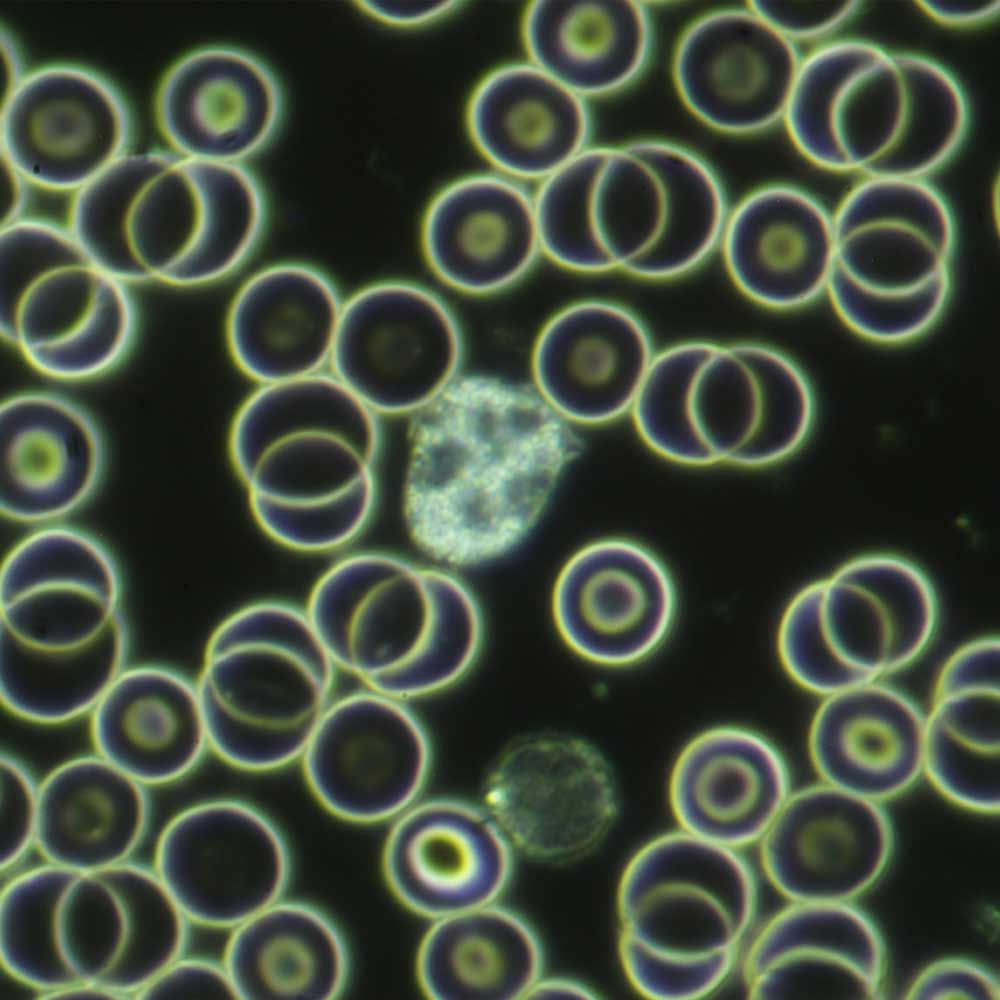
Live blood sample showingwhite blood cells before a session of PEMF therapy on CELLER8

When it comes to PEMF, there are two main ways to apply it: through localized applicators like the CELLER8 or our Mini Mat, or through larger mats, such as our full-body and travel mats.
Localized device / Mini Mat: If you want to focus PEMFs on a specific area of the body, a localized applicator is the perfect choice. This includes our CELLER8 localized device and the Mini Mat, both designed to target a smaller, defined area with precision. They’re particularly useful for on-the-go use. The CELLER8 can be strapped directly onto almost any part of the body, while the Mini Mat provides an excellent portable surface for focused sessions. These applicators allow you to give extra attention to injuries, sore muscles, or localised concerns whenever you need it.
Full-body / Travel Mats: That said, PEMF is most powerful when it’s experienced across the whole body. Why? Because the human body is holistic and interconnected from head to toe. Five major systems including circulatory, lymphatic, nervous, connective tissue, and meridian (primo vascular) link every cell, tissue, and organ into a single, dynamic network. To fully energise these systems, you need the wide coverage and deep penetration of a full-body mat. This way, all 37 trillion cells in your body receive the benefit of PEMF, not just the ones near a local applicator.
Even if you’re dealing with a local injury, such as a sprained ankle, a full-body session is still the best option. Healing requires far more than just the ankle itself, blood flow, nutrients, oxygen, immune support, and nerve signals from the entire body all have to mobilise toward the injury site. A full-body mat session helps “switch on” these global systems, laying the foundation for recovery. Once this foundation is activated, a local applicator like CELLER8 or our Mini Mat can then be used to intensify support directly at the site of pain or injury.
The Best of Both Worlds: That’s why we’ve designed our packages to combine both. With a full-body or travel mat, you energise the entire system, while the localized applicators allow you to double down on the areas that need the most attention. Used together, this creates what we call a “sandwich effect” with PEMF coming from multiple angles for deeper, more targeted application. This 2 in 1 approach ensures you don’t just support the surface-level problem but the whole-body processes that make healing possible.